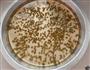
绿豆白凉粉的做法步骤7

| 食材名称 | 份量 | 热量 | 度量(每100克) | ||
| 绿豆 | 克 | 165千卡 | 329千卡 | ||
| 白凉粉 | 克 | 19千卡 | 37千卡 | ||
| 总量 | 100克 | 绿豆白凉粉热量/卡路里184千卡 | |||

1、准备食材。

2、绿豆洗净下锅煮熟。

3、白凉粉加入150ML冷水和开。

4、另取1100ML清水烧开,加入冰糖化开

5、加入煮熟的绿豆。

6、边倒入和开的白凉粉,边搅动。
7、再次煮开后,倒入容器里冷却即可。

8、切块即可食用。

9、倒入模具里做出来的造型更漂亮。
绿豆的热量329千卡(每100克);有利含量:低胆固醇,低钠盐,低饱和脂肪酸,富含维生素E,富含维生素B1,富含磷,富含钾,富含铁,富含蛋白质,富含膳食纤维;具有厚肠胃、抗过敏、利尿等功效;可与西瓜、百合、燕麦搭配;与紫米、棒子、番茄相克,同食可能会引起不适;
白凉粉的热量37千卡(每100克);有利含量:低胆固醇,低钠盐,低饱和脂肪酸;
© Copyright 2011 益优网 All rights reserved 版权所有
桂ICP备2020006802号-1